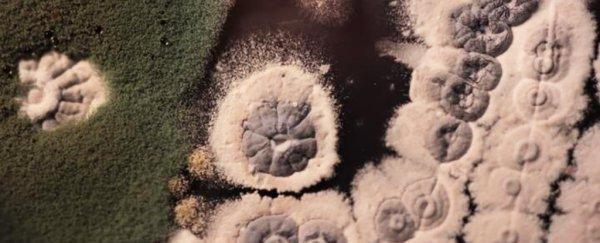
Antibiotic Biosynthesis and Antibiotic

Antibiotic Biosynthesis and Antibiotic Resistance Evolved Contemporarily in Bacteria: New Study
Image for representational use only.Image Courtesy : Science Alert.
Bacteria growing resistance to antibiotics and emergence of superbugs are serious concerns for both microbiologists and doctors. Increasing microbial resistance towards antibiotics has posed a new threat in the treatment of patients under severe bacterial attack. Efforts have been underway in understanding the evolutionary mechanism of this antibiotic resistance.
A recent study published in Nature Microbiology has reported that antibiotic biosynthesis in bacteria and that of antibiotic resistance could be mapped to approximately 150-400 million years ago. This happens to be the first study on antibiotic biosynthesis and antibiotic resistance in a truly evolutionary framework.
In the research, the team focused on glycopeptides, a class of antibiotics. Antibiotics such as vancomycin and teicoplanin belong to the class of glycopeptide antibiotics. The World Health Organisation has declared vancomycin as an essential medicine, which can be used as a large resort medication in some cases.
But, these antibiotics have also suffered a growing resistance from bacteria that are targeted with these antibiotics. The researchers hoped to shed some light on how the evolutionary race can be won in the future to fight back the resistance posed by microbes.
“The results we uncovered in this study offer a valuable lens through which to consider the current antibiotic crisis. Our study reveals several implications in how we could potentially manage antibiotic use and find new drugs for antimicrobial infections,” said Nicholas Waglechner, a biochemist in McMaster University, Canada and also the lead author of the study.
The team’s job was not easy though. It extracted the evolutionary history by first identifying the genome sequences that encode genes necessary for the production of glycopeptide antibiotics within actinobacteria, a group of bacteria found mostly in soil.
The team then plotted the changes that crept into the genes over time. Their findings revealed that the precursor genes responsible for glycopeptide antibiotic production in actinobacteria emerged over one billion years ago. But the production of the first ancestor of glycopeptide antibiotics like that of vancomycin emerged along with the resistance and can be dated back to 350-500 million years ago.
“The results we uncovered in this study offer a valuable lens through which to consider the current antibiotic crisis. These compounds have been useful to bacteria on the planet even before dinosaurs appeared, and resistance co-evolved with production as a means of self-protection for producing bacteria. The use of vancomycin in modern times in medicine and agriculture has resulted in the movement of resistance from these innocuous producers to disease-causing bacteria over a few short decades,” said Nicholas.
This is interesting. Actinobacteria produces glycopeptide antibiotics and it had also developed the resistance at the same time. Why at all this happened? Producing something and also developing the antidote to it at the same time? The answer could be that it gathered an evolutionary edge by this. The glycopeptide antibiotics damage the bacterial cell wall and hence, results in bacterial destruction. For survival under this family of antibiotics, a microbe must develop the trick that protects its cell walls from getting damaged. Actinobacteria understood this fact and developed the resistance against the antibiotic that is produced by actinobacteria itself. On the other hand, the actinobacteria glycopeptide antibiotics could destroy the cell walls of other categories of bacteria and thus provided actinobacteria with an edge for survival.
Now, the efforts would be to use this evolutionary information in handling microbial resistance towards essential antibiotics like vancomycin which is the main source of treatment of the deadly MRSA (Methicillin Resistant Staphylococcus Aureus).
Get the latest reports & analysis with people's perspective on Protests, movements & deep analytical videos, discussions of the current affairs in your Telegram app. Subscribe to NewsClick's Telegram channel & get Real-Time updates on stories, as they get published on our website.














